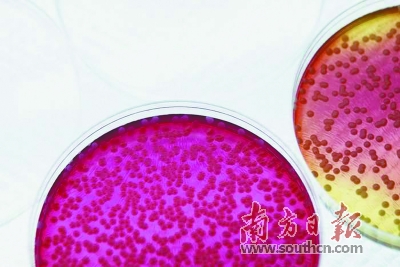

發(fā)布時(shí)間:2018-04-24來源:來源:南方日?qǐng)?bào)

如果心臟衰竭了,就有一個(gè)新的健康心臟“替換”,這個(gè)心臟是你自己“生產(chǎn)”的,不存在排斥反應(yīng);白血病患者可以移植來自自身的造血干細(xì)胞,這些造血干細(xì)胞經(jīng)過“改造”,不再攜帶致病基因……
4月6日,國(guó)際干細(xì)胞權(quán)威雜志《細(xì)胞·干細(xì)胞》發(fā)表了一項(xiàng)重大成果。歷經(jīng)5年探索,中科院廣州生物醫(yī)藥與健康研究院裴端卿領(lǐng)銜的科研團(tuán)隊(duì)研發(fā)出一套“魔法藥水”,成體細(xì)胞浸泡在其中,就能變成多能干細(xì)胞,實(shí)現(xiàn)了細(xì)胞層面的“返老還童”。
化學(xué)方法誘導(dǎo)多能干細(xì)胞的方式,使得安全高效制備干細(xì)胞成為可能,為器官再生提供了安全可用的多能干細(xì)胞來源。或許,未來如果器官組織損壞,就可以用自己的體細(xì)胞“生產(chǎn)”出一個(gè)新的用來更換!
●南方日?qǐng)?bào)記者 李秀婷 通訊員 黃博純 策劃統(tǒng)籌:李江萍
細(xì)胞“返老還童”的路徑
干細(xì)胞又被稱為“萬用細(xì)胞”,可以自我復(fù)制,在一定條件下可以分化成體內(nèi)所有的細(xì)胞,進(jìn)而形成身體的各種組織和器官。
每一個(gè)人都是從一個(gè)胚胎干細(xì)胞分化發(fā)育而來。胚胎干細(xì)胞是全能的,能發(fā)育出一個(gè)完整的個(gè)體。多能干細(xì)胞雖不能發(fā)育成完整個(gè)體,但具有分化出多種細(xì)胞組織的潛能。
多能干細(xì)胞進(jìn)一步分化,就會(huì)發(fā)展成能生成特定功能細(xì)胞的專能干細(xì)胞,比如造血干細(xì)胞能生成紅細(xì)胞、白細(xì)胞和血小板;皮膚干細(xì)胞則能產(chǎn)生各種類型的皮膚細(xì)胞。
多能干細(xì)胞在器官再生、器官修復(fù)和疾病治療方面極具應(yīng)用價(jià)值。但過去,人們認(rèn)為多能干細(xì)胞只能從胚胎中獲得,要將它應(yīng)用在醫(yī)學(xué)上,不可避免地會(huì)遭遇倫理問題。
因此,科學(xué)家們一直在“折騰”各種辦法,嘗試把已經(jīng)分化了的成體細(xì)胞變回多能干細(xì)胞。在細(xì)胞層面來說,這就是要“逆轉(zhuǎn)”細(xì)胞的命運(yùn),實(shí)現(xiàn)“返老還童”。
怎樣把一個(gè)成體細(xì)胞變成一個(gè)多能干細(xì)胞?論文共同通訊作者、中科院廣州生物醫(yī)藥與健康研究院研究員劉晶介紹,這一過程,專業(yè)術(shù)語叫做“重編程”,目前科學(xué)家們探索出了三種重編程方法。
第一種是核移植。核移植是將供體細(xì)胞的細(xì)胞核取出來,放入一個(gè)去掉細(xì)胞核的受體卵母細(xì)胞中,就能培育成胚胎,最終生下與供體基因完全一致的個(gè)體。這個(gè)過程就是大家熟悉的克隆,克隆羊多利就是使用這種方式誕生的。
但通過這種方式來獲得干細(xì)胞,不僅存在倫理問題,代價(jià)也很昂貴?!斑@種方式需要破壞一個(gè)卵細(xì)胞,而卵細(xì)胞比較難以獲得,成功率很低,要求很高?!眲⒕дf。
第二種方法是細(xì)胞融合,把一個(gè)體細(xì)胞與一個(gè)干細(xì)胞融合,也能讓這個(gè)體細(xì)胞具有一定的干細(xì)胞特征。但劉晶說,這樣形成的雜交細(xì)胞是多倍體,不具備臨床意義。
第三種方法就是誘導(dǎo)多能干細(xì)胞技術(shù)。2006年,日本科學(xué)家山中伸彌利用病毒作為載體,將4個(gè)轉(zhuǎn)錄因子的組合轉(zhuǎn)入分化的體細(xì)胞中,使其重編程,得到了類似胚胎干細(xì)胞的一種細(xì)胞。這種轉(zhuǎn)基因誘導(dǎo)產(chǎn)生的多能干細(xì)胞被稱為誘導(dǎo)多能干細(xì)胞(iPS)。
誘導(dǎo)多能干細(xì)胞甫一出世,就震驚了世界。2007年,利用iPS技術(shù),科學(xué)家們成功地將人的成體細(xì)胞誘導(dǎo)成幾乎與胚胎干細(xì)胞完全一樣的多能干細(xì)胞。2012年,山中伸彌因此而獲得諾貝爾獎(jiǎng)。
化學(xué)誘導(dǎo)“另辟蹊徑”
如今,全球不少科學(xué)家都投入了誘導(dǎo)多能干細(xì)胞的研究,發(fā)現(xiàn)了一些其他的基因組合也可以實(shí)現(xiàn)體細(xì)胞的“返老還童”。劉晶說,轉(zhuǎn)基因進(jìn)行重編程速度快,兩三天時(shí)間就能完成“返老還童”的過程,而且成功率高。目前轉(zhuǎn)基因誘導(dǎo)多能干細(xì)胞的成功率最高可達(dá)到50%。
但這類技術(shù)也有著明顯的應(yīng)用上的缺陷,最大的問題就是安全性。山中伸彌使用的4個(gè)轉(zhuǎn)錄因子中有些屬于原癌因子,如果轉(zhuǎn)錄到人的基因組中,有很大的引發(fā)癌癥的風(fēng)險(xiǎn)。病毒轉(zhuǎn)錄的方式,也可能會(huì)激活一些原癌基因,失活抑癌基因。
不少科學(xué)家一直在試圖找到用小分子化合物代替轉(zhuǎn)基因的方法,其中就包括裴端卿和劉晶領(lǐng)銜的團(tuán)隊(duì)。經(jīng)過5年的努力,他們最終開發(fā)出一套高效簡(jiǎn)單的化學(xué)誘導(dǎo)干細(xì)胞多能性的方法。
該方案只需要給細(xì)胞用兩種不同的“藥水”依次“泡澡”,便可以將體細(xì)胞的命運(yùn)“逆轉(zhuǎn)”到胚胎發(fā)育早期的多能干細(xì)胞狀態(tài)。更可貴的是,該方法可實(shí)現(xiàn)多種體細(xì)胞類型“返老還童”,包括在體外極難培養(yǎng)的肝細(xì)胞。
劉晶介紹,染色質(zhì)決定了細(xì)胞是多能干細(xì)胞狀態(tài)還是成體細(xì)胞狀態(tài)。如果把人體內(nèi)的染色質(zhì)拉成一條線的話,可能有2米長(zhǎng)。有的區(qū)段是包裝致密的狀態(tài),不表達(dá)信息,有的區(qū)段是松散打開狀態(tài),會(huì)表達(dá)信息,可以分別用計(jì)算機(jī)二進(jìn)制語言0和1來比擬。
2米長(zhǎng)的染色質(zhì)上有很多這樣0和1不規(guī)則的組合,像一個(gè)密碼串。在體細(xì)胞狀態(tài),密碼串是一種模式,在干細(xì)胞狀態(tài),這個(gè)密碼串又是另一種模式。要把體細(xì)胞狀態(tài)變成干細(xì)胞狀態(tài),就需要在一些關(guān)鍵的位點(diǎn)上,將成體細(xì)胞染色質(zhì)的開關(guān)閉合變得與干細(xì)胞一致。
最終,團(tuán)隊(duì)用一組化合物改變了細(xì)胞密碼串的開放閉合狀態(tài)。在第一次“泡澡”中使用的化合物組合,讓成體細(xì)胞的密碼串“動(dòng)起來”,染色質(zhì)轉(zhuǎn)化為中間態(tài),不再是被“鎖定”的狀態(tài);第二次“泡澡”使用了適宜多能干細(xì)胞生存的化合物藥水,誘導(dǎo)細(xì)胞轉(zhuǎn)化為多能干細(xì)胞。
為器官再造“鋪路”
“逆轉(zhuǎn)”細(xì)胞命運(yùn),靠的是一組化合物的共同作用。劉晶說,研究者們?nèi)孕枰闱宄恳环N化合物在群體中具體起什么作用,哪一種化合物更加關(guān)鍵,沒有它就達(dá)不到最終的效果。
劉晶團(tuán)隊(duì)研究了其中的一個(gè)關(guān)鍵小分子Brdu,發(fā)現(xiàn)它可以直接作用于DNA結(jié)構(gòu)本身,來調(diào)節(jié)染色質(zhì)的密碼狀態(tài)?!叭绻苎芯壳宄恳环N化合物的作用,就能更方便地對(duì)細(xì)胞的命運(yùn)進(jìn)行調(diào)控,定向地將一種細(xì)胞變成另一種細(xì)胞?!眲⒕?duì)此非常向往。
雖然屬于基礎(chǔ)性前沿研究,但這一成果卻有著非常良好的應(yīng)用前景。劉晶介紹,小分子化合物的誘導(dǎo)方式公認(rèn)比轉(zhuǎn)基因的方式更安全,因?yàn)闆]有引入外源基因,沒有直接對(duì)基因組造成大規(guī)模的插入和破壞。
此外,由于化學(xué)成分是確定的,就可以使用標(biāo)準(zhǔn)化自動(dòng)化的流程進(jìn)行工業(yè)化生產(chǎn),實(shí)現(xiàn)多能干細(xì)胞大規(guī)模擴(kuò)增;轉(zhuǎn)基因方式過程繁瑣,需要很高的實(shí)驗(yàn)操作技巧,而化合物誘導(dǎo)更簡(jiǎn)單、門檻更低,大家都可以用來開發(fā)治療疾病的新手段。
“接下來最關(guān)鍵的是把人的細(xì)胞實(shí)現(xiàn)純化合物的誘導(dǎo)?!眲⒕M?,可以利用這種化合物“泡澡”的方式,在人的細(xì)胞上也實(shí)現(xiàn)誘導(dǎo)多能干細(xì)胞,很多研究者都想先在猴子模型上完成這一步,并驗(yàn)證化學(xué)誘導(dǎo)出的多能干細(xì)胞能否培育成完整的成活個(gè)體。
不過,即使實(shí)現(xiàn)了人類細(xì)胞的化學(xué)誘導(dǎo)多能性,到底怎樣讓多能干細(xì)胞精確地分化成一種特定功能性細(xì)胞?“這一過程比重編程更難,效率更低?!眲⒕дf,目前只有很少種類的真正具有功能的細(xì)胞被人為分化出來,有的具有部分功能但還不能用以治療疾病。
“分化、再造某種我們需求的器官用以治療疾病的前提,就是要有安全可用的多能干細(xì)胞來源。我們現(xiàn)在就是先把干細(xì)胞做出來,這樣大家都可以用。”劉晶強(qiáng)調(diào)。
細(xì)胞何以“返老還童”?
第一次“泡澡”
使用化合物組合讓成體細(xì)胞的密碼串“動(dòng)起來”,染色質(zhì)轉(zhuǎn)化為中間態(tài),不再是被“鎖定”的狀態(tài)
第二次“泡澡”
使用適宜多能干細(xì)胞生存的化合物藥水,誘導(dǎo)細(xì)胞轉(zhuǎn)化為多能干細(xì)胞

(原載于《南方日?qǐng)?bào)》4月16日科技能見度 鏈接)
附件下載:

